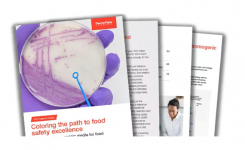
Agar plates with colorful microbial colonies on chromogenic media
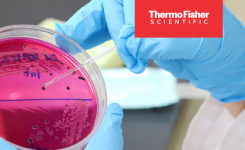
A close up of colonies on a pink agar plate

Thermo Fisher Scientific have introduced the Thermo Scientific™ Orbitrap Exploris™ EFOX Mass Detector, the industry’s first high-resolution accurate mass (HRAM) Orbitrap system designed specifically for environmental and food safety laboratories. The new system addresses urgent global challenges around food and water quality testing in the face of persistent contaminants, such as per- and polyfluoroalkyl substances (PFAS), pesticides and other pollutants. With tailor-made workflows and some of the strongest targeted analysis technology in the field, laboratories can use the Orbitrap Exploris EFOX (Environmental and Food Organic Xenobiotics) to generate richer, compliant data faster in order to assess public health risks sooner.
Unlike traditional high-resolution systems, which are typically research platforms retrofitted to handle routine testing, the Orbitrap Exploris EFOX delivers research-grade performance that is purpose-built for everyday workflows. It brings the award-winning Orbitrap technology used for deep protein and small molecule analysis into routine labs, enabling extremely low-level PFAS detection with the same confidence and precision. With intuitive operation and minimal setup, labs can move from sample to result in minutes – without sacrificing data quality or throughput.
“As environmental and food safety laboratories face mounting pressure to deliver faster, more accurate results under tight budgets and stringent regulatory requirements, the Orbitrap Exploris EFOX significantly lightens the workload for PFAS, pesticides and other contaminant testing,” said Lidija Raicevic, vice president and environmental and food safety lead, Thermo Fisher Scientific. “Offering an easy-to-use high-resolution mass detector helps ensure more labs can conduct critical full-scan, accurate mass high-resolution data monitoring, provide local testing across more areas of concern and ultimately accelerate quality controls to make our environment and food safer.”
The Orbitrap Exploris EFOX raises the bar in environmental and food safety testing by capturing full-scan, high-resolution data from every sample. This comprehensive data collection enables retrospective analysis, allowing labs to search for newly identified compounds without reinjecting samples, saving time and staying ahead of evolving regulatory requirements. Additionally, built-in workflows for key environmental contaminants help labs achieve compliance faster, eliminating months of method development and reducing operational costs.
The system is seamlessly integrated with the Chromeleon™ Chromatography Data System (CDS), offering a guided, intuitive interface that simplifies processing and reporting. This minimizes training needs, reduces review cycles and accelerates the delivery of critical health and safety insights. And the system’s robust and reliable performance with the coupled Thermo Scientific Vanquish™ dual channel UHPLC offering adds confidence, flexibility and productivity to the overall solution.
In addition to the Orbitrap Exploris EFOX, Thermo Fisher Scientific will continue to support triple quadrupole workflows with the Thermo Scientific TSQ Altis™ Plus EFOX MS – a dedicated edition of the TSQ Altis Plus mass spectrometer optimized for environmental and food analysis.
To learn more about the Thermo Scientific Orbitrap Exploris EFOX Mass Detector, please visit: thermofisher.com/EFOX.